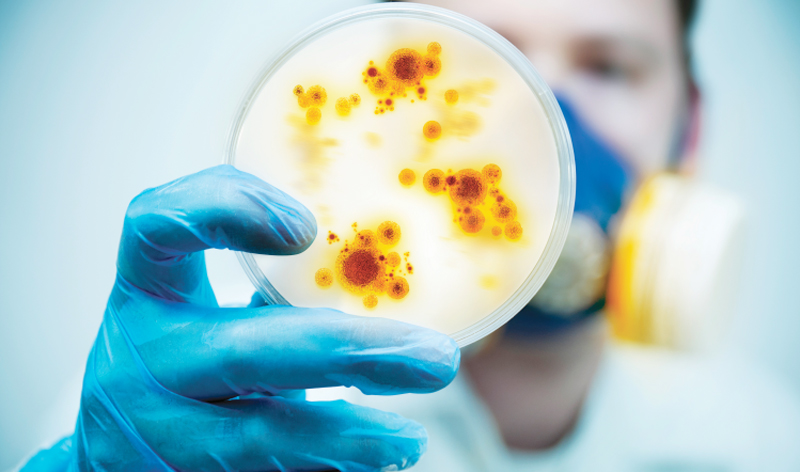

WHO announces new names for Monkeypox virus variants using Roman numerals
SWITZERLAND: A group of global experts convened by the World Health Organisation (WHO) agreed on new names for Monkeypox virus variants, as part of ongoing efforts to align the names of the Monkeypox disease, virus and Variants — or Clades — with current best practices. The experts agreed to name the Clades using Roman numerals.
The Monkeypox virus was named upon first discovery in 1958 before current best practices in naming diseases and viruses were adopted. Major variants were identified by the geographic regions where they were known to circulate.
Current best practise is that newly-identified viruses, related diseases, and virus variants should be given names with the aim to avoid causing offense to any cultural, social, national, regional, professional, or ethnic groups, and to minimize any negative impact on trade, travel, tourism or animal welfare. A consensus was reached to now refer to the former Congo Basin (Central African) clade as Clade one (I) and the former West African clade as Clade two (II).
Thus, the new naming convention comprises Clade I, Clade IIa, and Clade IIb, with the latter referring primarily to the group of variants mainly circulating in the 2022 global outbreak.
The naming of lineages will be proposed by scientists as the outbreak evolves. Experts will be reconvened as needed.
The new names for the Clades will come into effect immediately while work continues on the disease and virus names.
– INDIA TODAY